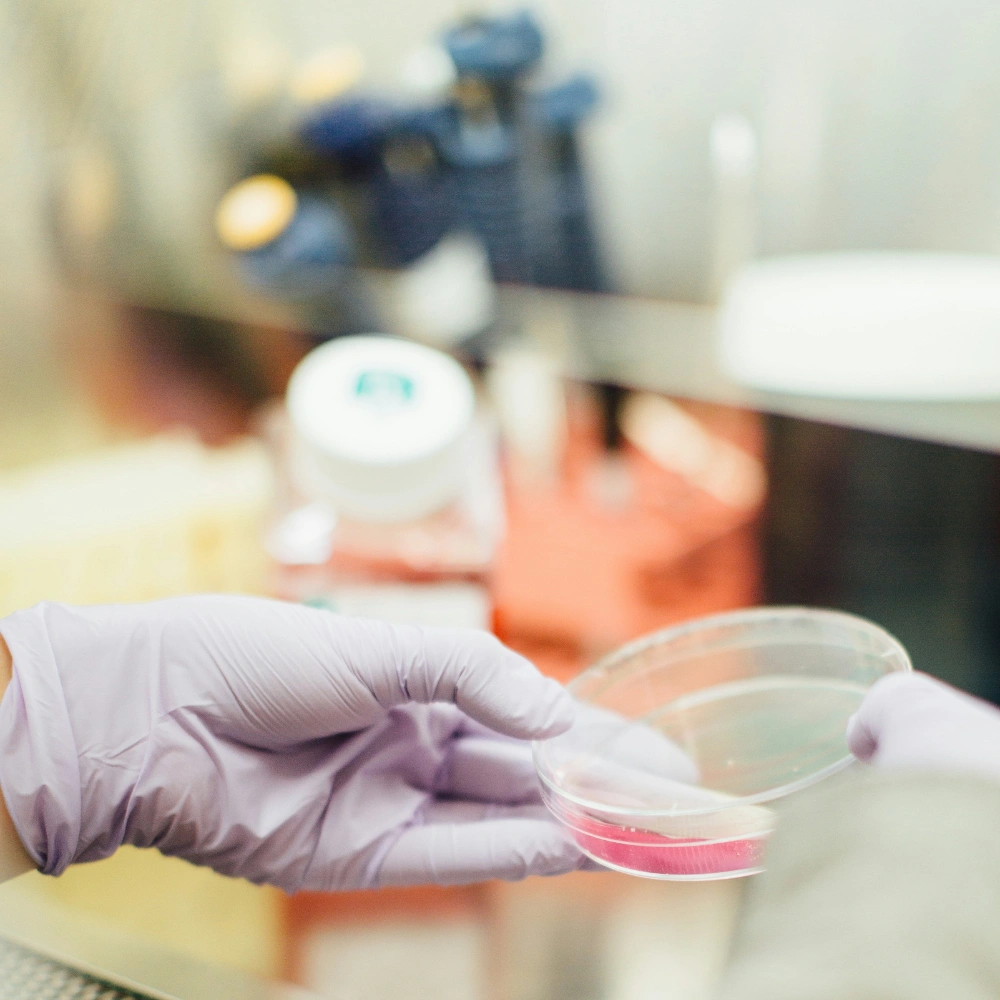
pharmaceutical

Talent
Jij kent je vak, wij de markt.
Samen bepalen wij de koers.
Geen standaard plaatsing, maar een gerichte stap naar jouw ideale scenario: inhoudelijk, persoonlijk en toekomstgericht.
Ontdek in welke sectoren wij actief zijn, welke disciplines wij bemiddelen en wie jouw aanspreekpunt is bij FORZ.
Life Sciences
Biotechnologie, farmaceutische productie en medische technologi.

Petrochemie
Procesindustrie, raffinage en chemische installaties.

Duurzame Energie
Wind, zonne-energie, waterstof en andere hernieuwbare technologieën.

Maritiem
Scheepsbouw, maritieme techniek en onderhoud aan vaartuigen en installaties.

Offshore (Olie & Gas)
Platformbeheer, pijpleidingen, onderhoud en technische functies binnen de olie- en gasindustrie.

Aerospace & Defensie
Lucht- en ruimtevaarttechniek, defensiesystemen en veiligheidstechnologie.
Jouw aanspreekpunt bij FORZ
Elke discipline heeft z’n specialist. Neem direct contact op met de consultant die jouw vakgebied vertegenwoordigt.

Yigal Fortuin
Project & Construction Management
y.fortuin@forzconsultancy.com

Ben Roz
Health Safety & Environmental
b.roz@forzconsultancy.com

Maxime Speets
Operations Coordinator
m.speets@forzconsultancy.com

Helena Siaila
Consultant Commissioning
h.siaila@forzconsultancy.com

Jasper Bos
Consultant Construction Management
j.bos@forzconsultancy.com

Max Haagsma
Consultant HSE
m.haagsma@forzconsultancy.com

Laas Poelhekke
Consultant Engineering
l.poelhekke@forzconsultancy.com
